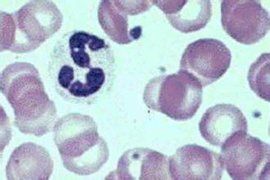
白細胞增多 白細胞增多

白細胞是血液中一類細胞的總稱,主要包括單核細胞,淋巴細胞,中性粒細胞,白細胞的正常值是4-10x10-12/ml,高於這個範圍稱為白細胞的增多。常見於急性感染,慢性感染等各種細菌或病毒感染性疾病。
有炎症的時候,血液,尿液裡面的白細胞就會增加。還有一些血液病的白細胞也會增加 。
此外醫生常常要根據血常規中的白細胞狀況進行分析,判斷患者是否存在感染。一般來講感染會引起白細胞增高。但某些白細胞增高不一定就是存在感染。
許多生理因素可以引起白細胞總數增加。比如:劇烈運動;體力勞動;在冬季長時間暴露於冷空氣之後;飽餐、淋浴後也常有白細胞輕微增高。生理性白細胞增高還見於情緒緊張,飢餓時低血糖等。但生理性白細胞增多是暫時的,去除影響因素則很快恢復。產生機制可能是與各種生理因素刺激時,體內兒茶酚胺分泌增多,導致邊緣白細胞進入循環所致。
許多藥物可以引起白細胞總數增加。比如:某些抗生素如紅黴素、頭孢賽曲等;還有兒茶酚胺類藥如腎上腺素、去甲腎上腺素、間羥胺、多巴胺等;另外腎上腺皮質激素氫化可的松、地塞米松、促腎上腺皮質激素等均可引起白細胞總數增多。抗精神病藥碳酸鋰也可以引起白細胞數量增多。
總之,血常規中白細胞增高不一定是感染,很可能是由於上述生理因素或藥物所致.血液病的白細胞也會增加 。
相關詞條
-
中性白細胞增多症
中性粒細胞增多症(n 中性粒細胞在骨髓中生成源於造血幹細胞。 外周血中性粒細胞增多的機制有三:
簡介 中性白細胞增多症的病因 中性白細胞增多症的檢查 中性白細胞增多症的併發症 -
白細胞疾病
白細胞疾病包括白細胞減少症、粒細胞缺乏症、嗜酸性粒細胞增多症、急性白血病、慢性白血病、骨髓增生異常綜合症、惡性淋巴瘤(霍奇金淋巴瘤、非霍奇金淋巴瘤)、傳...
簡介 疾病分類 白細胞疾病的治療 病因 -
中性白細胞
中性白細胞(Neutrophil,或Neutrophil granulocyte,又譯中性粒細胞、中性白血球)是血液中血細胞成分之一。胞內富含溶酶體酶等...
簡介 來源 含量 結構特點 作用 -
紅細胞增多
紅細胞增多指單位容積血液中紅細胞數高於正常值高限。一般認為經多次檢查成年男性紅細胞>600萬/mm3,成年女性>550萬/mm3,就屬紅細胞增多。相對性...
症狀診斷 鑑別診斷 -
白細胞計數
白細胞計數,是指計數單位體積血液中所含的白細胞數目。舊稱白血球,是機體防禦系統的重要組成部分。
基本介紹 正常範圍 臨床意義 相關疾病 -
尿白細胞
尿白細胞,是正常情況下白細胞存在於血液中,但由於一些原因部分白細胞混入尿液就形成尿白細胞。
定義 尿液常規 化驗意義 -
白細胞破壞性脈管炎
白細胞破壞性脈管炎(leukocytoclastic vasculitis)是由多種原因致敏引起的,累及皮膚和(或)內臟的小血管——主要是毛細血管後靜脈...
發病機制 症狀 診斷 鑑別診斷 檢查 -
白細胞稀釋液
白細胞稀釋液,用於白細胞的稀釋,便於顯微鏡下白細胞的計數。
簡介 作用 檢測結果 注意事項 -
醛固酮增多症
醛固酮增多症是由腎上腺皮質分泌過多的醛固酮而引起的高血壓和低血鉀綜合徵。Conn於1955年首先指出腎上腺皮質腺瘤分泌過多的醛固酮是本病的原因,因此又稱...
概述 疾病檢查 臨床症狀 治療方法 飲食注意